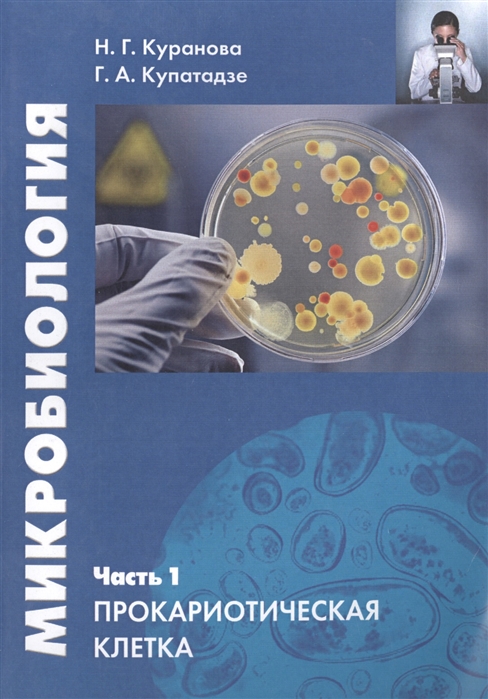

25430 3E401 китайский новый резервуар для охлаждающей жидкости для Kia Sorento 2.4L резервуар радиатора с крышкой трубки 25430-3E401
Price history chart & currency exchange rate
Customers also viewed

$166.51
20 см спереди шнуровка рыбий рот тонкий каблук высокий каблук низкие сапоги ночной клуб сцена шест танец на высоком каблуке подошва короткие сапоги 34 красный
joom.ru![Кружка NORDISK Outdoor Camp Madam Blue эмалированная Bla Sky Blue S 250 мл, японская 119082 (Мадам Кубок) [Подлинный продукт] небесно-голубой
Кружка NORDISK Outdoor Camp Madam Blue эмалированная Bla Sky Blue S 250 мл, японская 119082 (Мадам Кубок) [Подлинный продукт] небесно-голубой](http://img.joomcdn.net/6c24db2a9365fbc0b52ed64cbaa73f47ca247605_original.jpeg)
$55.29
Кружка NORDISK Outdoor Camp Madam Blue эмалированная Bla Sky Blue S 250 мл, японская 119082 (Мадам Кубок) [Подлинный продукт] небесно-голубой
joom.ru
$366.25
Android 14 Bluetooth Wireless CarPlay для Toyota RAV4 2007-2011 сенсорный экран стерео автомобильное радио мультимедийная навигация головное устройство
joom.ru
$67.56
American retro ballet training shoes women s 2024 new heightening non-slip outdoor casual versatile sports Forrest Gump shoes 35
joom.ru
$24.32
Silikoni iskunkestävä ja vahvistetut kulmat cover "Kultaiset mansikat" for Tecno Spark 10C, Musta
endorphone.com.ua
$12.60
Для Braun Series 5/6 Braun Shaver 53B, Сменная головка для смартфона 50-R1000S/50-B1300S 6075Cc 6020S
aliexpress.ru
$8.59
Дорожная персональная сумка через плечо с защитой от кражи, спортивный беговый Невидимый кошелек, удобная Многофункциональная Мужская нагрудная сумка с защитой от брызг
aliexpress.ru
$4.96
DuoShang New Style Animal Dog Acetate Hair Claw Cute Cartoon Schnauzer Claw Clip Crab Hair Clip for Women Girls Hair Accessories
aliexpress.ru
$15.28
Music Lover Tee shirt Tops Vintage Violin Gift T-shirt For Violinists Awesome Orchestra Men's Retro Violin Long Sleeves T shirts
aliexpress.com
$4.47
SADOER 20g Aloe Pomegranate Vitamin C Eye Cream Hydrating Moisturizing Eye Grain Care And Mild Desalinating Fine Cream N8T4
aliexpress.com
$30.01
Brown Storage Fabric Ottoman Bench Poop stool Telescoping stool Folding step stool Telescopic stool Folding stool Pouf ottoman S
aliexpress.com
$5.74
High-density Board Halloween Tag Led Light Halloween Door Sign Wooden Pumpkin Ghost Wall Hanging Decoration for Indoor Outdoor
aliexpress.com
$22.50
RELIFE RL-601I Mini Fixture Motherboard Chip BGA for Mobile Phone PCB Multi-function Clamp IC Murization Tin Planting Table Jig
aliexpress.com
$2,571.40
Upgraded Version Magnetic Stimulation HI-EMT Muscle Stronger Fast Building Body Sculpture Machine With 4 Handls 5000W Big Power
aliexpress.com
$6.98
20/50/100Pcs Pitch 7.62mm Barrier Screw PCB Terminal Block 25S-A Morsettiera Straight 2/3/4/5/6P Wire Cable Connector Bornier
aliexpress.com
$8.45
6Pcs LED Lamps Candle Light Bulbs Candlesticks 2700K AC220-240V, E14 470LM 3W Cool White
aliexpress.com
$0.89
5M Star Wire Garland Christmas Party Star Foil Tinsel Rattan Festive Valentine's Day Decoration DIY Crafts Party Supplies
aliexpress.com
$32.60
Chemin de lit d'hôtel, écharpe de queue de lit, simple, moderne, chinois, or, couvre-lit, coussin de queue, taie d'oreiller câlinante
miniinthebox.com
$42.15
neutral perfumes 80ml 100ml parfums fame rechargeable refillable edt perfume eau de parfum lasting smell robot mango lemon cologne for male
dhgate.com
$34.53
h.sa winter sweater cardigans v neck button up casual long coat warm thick argyle vintage knitting jacket 210417, White;black
dhgate.com
$90.61
fashion paris 17fw triple s men sneaker casual dad shoes for man women black white red yellow grey sports sneakers size 36-45
dhgate.com
$12.47
The Letter to the Hebrews: Volume 11 (Volume 11) (New Collegeville Bible Commentary: New Testament)
abebooks.com
$103.50
Eioupi New Arrival Classic Real Full Grain Leather Cowhide Lining Men's Business Black Dress Shoes
aliexpress.com
$202.00
Формовочная машина для булочек из нержавеющей стали, высокоэффективный производитель Baozi в столовой, ресторане
aliexpress.com
$7.70
Ультразвуковой ирригатор, зубной скалер, татар для отбеливания зубов, устройство для чистки зубов, калькулятор зубного налета, инструмент д...
aliexpress.ru
$15.74
Портативная подушка на сиденье для стадиона, сверхтолстые встроенные карманы для дома и улицы, складные подушки для стула с плечевым ремнем...
aliexpress.ru
$30.47
yoga outfit fashion women bandage pants lace-up women's suede leather pencil lace up cut out sportswear trousers
dhgate.com